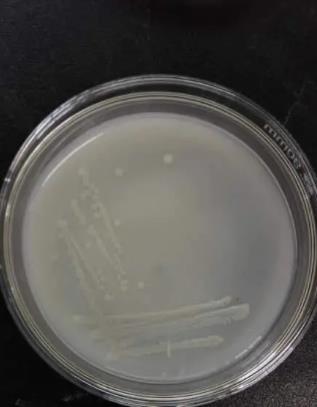
解磷菌是什么菌？解磷微生物種類及分布

本研究從不同養(yǎng)殖場的水產(chǎn)養(yǎng)殖樣品中分離出6株耐藥弧菌,其中3株溶藻弧菌和Vp.W1具有阿莫西林、氨芐青霉素和哌拉西林三重耐藥性,Vs.W2和Vm.R3 ...
歡迎來到BioSense網(wǎng)站!
歡迎來到BioSense網(wǎng)站!

本研究從不同養(yǎng)殖場的水產(chǎn)養(yǎng)殖樣品中分離出6株耐藥弧菌,其中3株溶藻弧菌和Vp.W1具有阿莫西林、氨芐青霉素和哌拉西林三重耐藥性,Vs.W2和Vm.R3 ...

采用改良后的紫外分光光度法檢測弧菌的生長情況。將分離的弧菌轉(zhuǎn)移到3%NaCl胰蛋白胨大豆肉湯(TSB)中培養(yǎng)獲得菌懸液,通過稀釋分別獲得1.0×105 ...

本文以裂片石莼為代表性海藻,分析不同條件下裂片石莼水培液的組成成分及其對分離到的不同耐藥弧菌株的抑菌作用,以期對海水養(yǎng)殖弧菌病害的預防和治療提供參考。 ...

?典型的傳統(tǒng)細菌計數(shù)方法主要有平板計數(shù)法和最大或然計數(shù)法(MPN法)等等,這些方法均在固體或液體培養(yǎng)基中對待測菌種進行培養(yǎng),然后根據(jù)培養(yǎng)后顯現(xiàn)出的宏觀 ...

本研究選取2020年9月—2023年9月哈密市中心醫(yī)院收治的70例尿路感染患者及70例周期接受健康體檢人群為研究對象,分析尿常規(guī)檢驗的診斷價值,現(xiàn)報道 ...

?耕地土壤中磷素含量普遍不高,再加上土壤中對磷素的固定作用,導致磷肥利用效率較低。解磷菌具有提高土壤有效磷含量、減少磷肥使用量及促進植物生長的作用。 ...
解磷菌一般指通過菌體生長繁殖過程中分泌的代謝物或者與其他菌體協(xié)同產(chǎn)生某些作用,將難溶性的磷轉(zhuǎn)化為能被植物吸收的有效磷,便于植物直接吸收利用。根據(jù)解磷菌 ...

分析GTF相關(guān)基因的表達水平和葡聚糖產(chǎn)量,以評估棉子糖對S.mutans GTF的影響。如圖4A所示,在1000μM棉子糖處理的S.mutans生物膜 ...

?變異鏈球菌(Streptococcus mutans)是一種具有代表性的生物被膜細菌,它通過葡糖基轉(zhuǎn)移酶(glucosyltransferase,G ...

?腸道的微生物群,也稱腸道菌群,具有地方外來病原菌定殖的能力,稱為定殖抗性。近年來抗生素治療導致微生物多樣性喪失,削弱了腸道菌群的定殖抗性,使得細菌病 ...